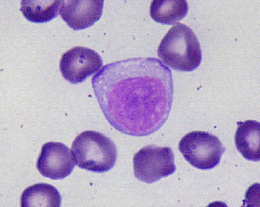

手相の四角 (404 無料写真)
手相紋占い6-2 手のひらの掌線上に井の字やスクエア 四角紋 がある手相簡単な手相の見方を伝授します。
手相占い 四角紋による一発逆転度MIRRORZ ミラーズ無料の心理テスト・診断・占い。
手相にスクエアは一発逆転サイン?意味や場所について解説 - zired。
手相占い 木星丘でわかる将来性MIRRORZ ミラーズ無料の心理テスト・診断・占い。
手相占い!スクエア 四角紋 のある意味15選!一発逆転・九死に一生・守られるなど!uranai cafe Quartz 占いカフェクオーツ。
他の投稿はこちら▶︎ @tesou_ysokit , あったら嬉しい手のひらの四角, みんなはあったかな?, 詳しくはコメント欄から☝️,手相 手相鑑定 占い,性格診断自己分析。
手相 地丘にスクエアがある人の実態 - 人生しんどい。
運命線 手相占い完全ガイド 人生を占う運命線の見方を知ろう! - 占いの森。
手相 占い」大串ノリコ先生監修!好きな人との相性、勉強運、適職など、気になることを占おう! 高校生なうスタディサプリ進路 高校生に関するニュースを配信。
手相 地丘にスクエアがある人の実態 - 人生しんどい。
エレメント手相 手のひらの形×指の長さでわかる手相属性 「火地風水」どの性格になる? - 占いTVニュース。
手相鑑定 自然と人が集まってくる人気者。パートナーとの将来を進展させる秘訣は?<44歳女性>。
小指の付け根『四角紋』 仕事・お金の課題、乗り越える御守り手相占い当たりすぎ手相占い手相鑑定四角紋スクエア手相診断TikTok。
手相にでるスクエア 四角紋・シャープ の基本的な意味を、初心者向けに解説 - 手相の見方大事典テソペディア。
テソーミ入門誰でもできる手相観ガイド』 — 日笠雅水 著 — マガジンハウスの本。
四角紋の見方特徴別に解説するビジュアル手相占いアリスの占い館。
手相に星「スター線」があると幸運!宝くじが当たるって本当!? – バランガンメディア。
運命線とは?特徴別の手相の意味と見方3選! 資格のキャリカレ。
掌の記号の種々相―星型と十字型 - 札幌の占い師「波木星龍」公式サイト占いアドバイス「開運占い師」。
手相紋占い6-1 手のひらに井の字 のようなスクエア□ 四角紋 がある手相。
手相の見方を解説!女性が気になる右手・左手別の手相の占い方│資格のキャリカレ。
伝える・教える が得意な手相人差し指の下あたり 木星丘 にマス目のような四角があれば、自分の経験や知識を伝えたり教えたりする優れた技術を持つ人です。このマス目はティーチャーズスクエアとか聖職紋と呼ばれています。 すでにそのような仕事をしている方もいれ。
手相占い!スクエア 四角紋 のある意味15選!一発逆転・九死に一生・守られるなど!uranai cafe Quartz 占いカフェクオーツ。
人差し指の下にシャープ の手相があるとどうなる?スクエアは教育者向き!! - ジャンボ宝くじの教科書。
手相「スクエア紋 四角紋 」は、一発逆転ホームランも夢じゃない人生迷子!起業迷子が生き方考え方を身につけるブログ @ちづる姐さん。
スクエア 四角形 がある感情線無料占い☆本格鑑定。
手相、四角感情線と知能線の間に四角があります。分かる方いれば見てください。- Yahoo!知恵袋。
手相占い 木星丘 人差し指の下 の見方を占い師が教えます! 縦線や横線の意味は?Oggi.jp。
手相における四角紋 スクエア の手相の意味は?シャープ ひし形 井型 ダイヤCuty。
手相占い 井の形をした「スクエア」 四角紋 の見方と意味Fortune Media。
石切 占い 手相のお話し 四角のしるし大阪石切占い 池田侑未ブログ。
四角紋は周りの支えでトラブルや試練を乗り越えられるという幸運の証 運命線上に現れた四角紋は運命線の交差の角度や位置で発生するトラブルの時期や内容をある程度予測することができる運命線に重ならない場合紅琶菟羽98% くわっぱ。
手相鑑定 自然と人が集まってくる人気者。パートナーとの将来を進展させる秘訣は?<44歳女性>。
ボランティア線コワイほど当たる! 手相占い芸人・島田秀平さんの最強手相占い! お仕事編占いnon-no web。
知っておきたい幸せになれる手相学 : チャートですぐ分かる!すぐに使える手相の- メルカリ。
運命線とは? 濃さ・長さ・形別の意味と見方 手相占い1ページ目 「マイナビウーマン」。
転職を機に大躍進する人にある手相を解説👐 \他の投稿はこちら@tesou_ysok -------------------------中学生の頃から手相を独学 『知らない自分を知る手相』 をコンセプトに活動中✋ @tesou_ysok ------------------------手相占い知らない自分を知る。
勝田名人@10 25㈯〜湘南台ファンタジア初参加🎤・原谷公園13:05〜 on X:"昨日何気なく手のひら見てたら、真ん中にスクエアのしわが出来てる!!運命線が薄いから重なってるのかわからないけど、重なってれば良い運気だった様な !?手相占い https:t.co。
手相についてです。中指の下に四角が出てきました。手相が以前より変- Yahoo!知恵袋。
手相の運命線にある四角紋 スクエア は「一休み」のサイン! - 手相LABO 星健太郎 Hoshi。
手相占い!スクエア 四角紋 の意味8選!運命線に現れると一発逆転?! - 手相占いラボ。